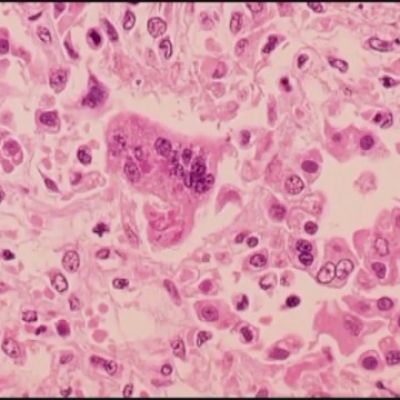

Madera County, California News
FollowThank you for following Madera County, California. You will receive email notifications for this topic. To make changes to this, please visit your account.
You need to upgrade in order to follow more topics and receive email notifications about new articles and ratings, as your subscription allows only topic(s). To change which topics you follow, please visit your account.

ABC30 News
YourCentralValley


